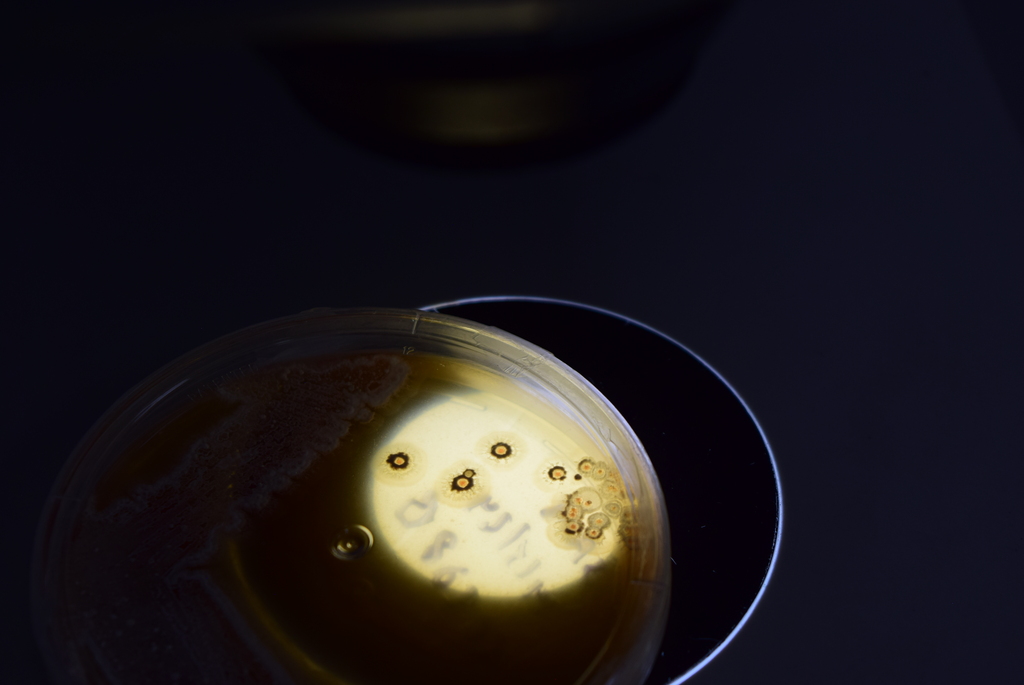

Our current workshop


Everything is about sharing
BGC-LATAM uses a standardized, end-to-end workflow to turn samples from Latin American ecosystems into comparable genomic and metabolomic datasets. With local partners and appropriate permits, we generate isolate genomes, metagenomes, or both, following shared protocols for sequencing and quality control.
We then combine genome mining of biosynthetic gene clusters (BGCs) with LC–MS/MS metabolomics and molecular networking (e.g., GNPS) to link genes to chemistry and compare biosynthetic diversity across regions, while ensuring proper attribution and responsible data sharing.
This year we have designed a modular course covering natural products, biosynthetic gene clusters (BGCs), genome mining, metabolomics, and eco-evolutionary principles. Sessions combine live classes, invited lectures, and hands-on MIBiG annotation sprints.
These short sessions are designed to help participants align on core concepts, tools, and shared workflows before the main workshop. We will cover essential background, expected formats for data and metadata, and practical guidance so everyone arrives prepared to contribute and collaborate effectively.
Find previous lectures here --> https://nselem.github.io/2022-06-13-GenomeMining-online/.
Lorem ipsum dolor sit amet, consetetur sadipscing elitr, sed diam nonumy eirmod tempor invidunt ut labore et dolore magna aliquyam erat, sed diam voluptua.

(work in progress)

(work in progress)
(work in progress)
BGC-LATAM is more than a network—it is a shared effort to reveal the hidden chemical diversity of Latin America. This map brings together the researchers, institutions, and territories that are part of that mission. It celebrates the region’s biological richness, the strength of collaboration, and the idea that by working together across borders, we can better understand and unlock the biosynthetic treasures of our ecosystems.







Get in touch to join as a sampling site, an analytical node, or a bioinformatics collaborator.
isolates
Students
BGC
Metabolites